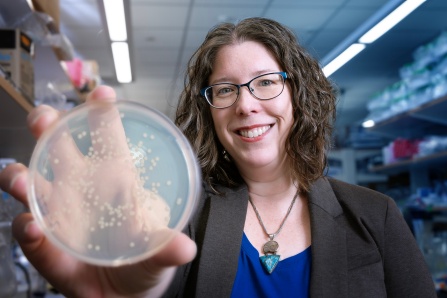
Chelsie Armbruster holding a petri dish with bacteria growth.

Our research opportunities include summer or academic year fellowships sponsored by professional societies, volunteer positions in both basic and clinical sciences faculty labs, work in school-affiliated research centers, and independent study to develop honors theses.
Fighting serious infections linked to medical devices
Dr. Armbruster studies why some urinary tract infections become severe, especially in people who rely on long-term catheters.
Her work helps scientists design better ways to prevent and treat hospital-acquired infections, improving care for vulnerable patients.
Understanding the link between the brain, inflammation, and mental health
Dr. Ignatowski’s lab explores how inflammation in the brain affects chronic pain, depression, and mood disorders.
This research helps improve treatments for chronic pain and mental health conditions, offering hope for patients whose symptoms don’t respond to traditional therapies.
Preventing complications of diabetes
Dr. Wang’s lab investigates how diabetes damages blood vessels throughout the body, especially in the eyes and kidneys.
This research supports the development of new therapies to prevent blindness, kidney disease, and other serious diabetic complications.
Stopping gum disease before it starts
Dr. Sharma studies the bacteria responsible for severe gum disease and tooth loss.
His work aims to prevent periodontal disease, improving oral health, and reducing links between gum disease and overall health problems.
"I’m part of a research team studying p-cresol, a compound found in patients with chronic kidney disease, focusing on how it moves across cell membranes. It’s incredibly meaningful to contribute to research that could help us understand this disease better and one day improve patient care in my community."
"Our lab is working on improving chemotherapies for various cancers that have been historically difficult to treat, including uveal melanoma, lung, and colon cancers. A common roadblock in both treatment of patients with existing therapies and availability of new treatment avenues is a medication's lack of effect on its own. We are investigating to see if certain combinations of these drugs work better together than separately based on what each drug targets in a cancer cell."
"My research in the Nutrition and Health Lab focused on how everyday stress can affect the health of teenagers. We studied whether higher stress levels are linked to higher body mass index (BMI) and whether these effects are different for males and females. Overall, this research helps show how stress can play an important role in teen health and well-being."
"I started off in Dr. Armbruster’s lab learning techniques such as machinery usage, safety protocols, and microbiology experiments surrounding CAUTI (Catheter-associated Urinary Tract Infections). Then, through a collaboration with Dr. Patrick Kenney’s lab, I was presented with the opportunity to study the phenotypic traits of a persistent isolate derived from a patient's medical device. This characterization included motility patterns, reactions under different environmental conditions, and structural attacks."
The Experiential Learning Network is the University at Buffalo’s central resource for hands-on learning.
The Project Portal and ELN Digital Badges are designed to help you find the best opportunities to build experience for your career and demonstrate your skills to future employers and graduate schools.
MIC 498 is an exciting opportunity to earn credit toward your major while actively engaging in biomedical research. Working closely with a faculty research mentor, you will help shape your experience by deciding together on your time commitment, research activities, and project goals. Along the way, you’ll strengthen your communication skills through presentations and written work, culminating in a final report summarizing your accomplishments.
CLIMB UP for Summer Research is an interdisciplinary, 9-week-long summer research program for undergraduates to conduct research in the biomedical, behavioral, and health sciences.
The CLIMB UP program provides research mentoring and career and professional development tailored to the goals of each of its divisions defined by research themes and sources of funding. Students explore graduate and career opportunities, discuss and present their research, network, and participate in social activities.
Is selecting a research mentor in your near future? Already feeling overwhelmed by the process?
Don't worry, we've compiled a workbook just for you! How to Choose a Mentor: 7 Steps to Find the Perfect Match is available to download at the link below.
You'll learn what makes a good mentor, how to prioritize your wishlist, how to craft an introductory email, and so much more. Download your workbook, and get started today!